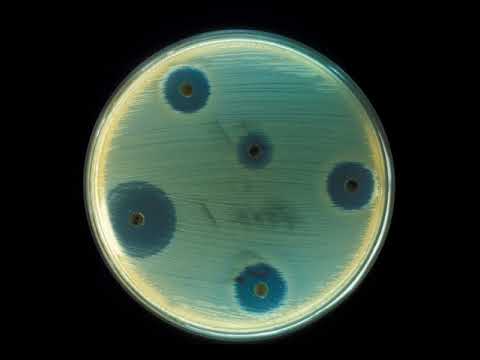

Loading song details...
Antibiotics AUDIO Long
No description available.
MP3 Download
Video Download
Related Songs

1:28:52
Antibiotics AUDIO Long

7:36
Antibiotic Classes In 7 Minutes

2:17:47
Antibiotics

1:09
Why Hydrogen Peroxide And Not Antibiotics

10:01
Amoxicillin Antibiotic DMF Audio Analog

13:17
Doxycycline Antibiotic Frequency Sound Healing Rife Hz

53:16
When Antibiotics Don T Work Full Documentary FRONTLINE

7:30
How To Mitigate The Risks Of Taking Antibiotics Peter Attia Colleen Cutcliffe

6:06:06
741Hz Cleanse Infections Dissolve Toxins Boost Immune System Naturally

2:17
How Long Should You Take Antibiotics After Plastic Surgery David Reath Knoxville Surgeon

3:55
The Science Of Antibiotics How They Work And Why Matter

22:50
Antibiotics And The Microbiome A Double Edged Sword NO MUSIC Better Audio

19:47
What Happens When You Take Antibiotics Side Effects

56:04
Antibiotics Wikipedia Audio Article
44:35
Antibiotics Wikipedia Audio Article

54:07
History Of Antibiotics Wikipedia Audio Article

51:09
History Of Antibiotics Wikipedia Audio Article

3:11
The Hidden Dangers Of Antibiotics For Kids Long Term Side Effects You Need To Know

5:41